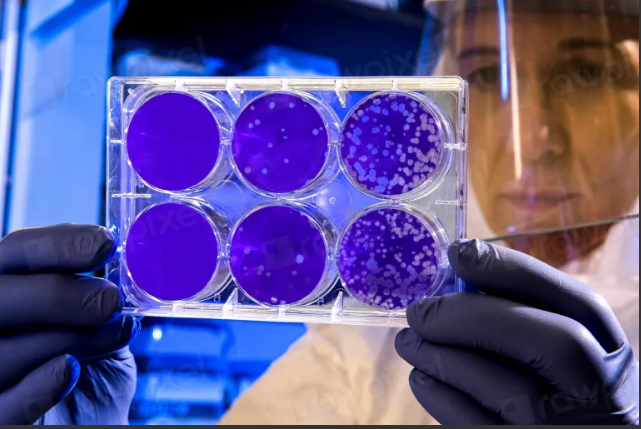
호흡기세포융합바이러스(RSV)

RSV 바이러스, 감기와 차이, 예방 및 치료법 소개.
영유아 및 노인 건강 관리 방법 RSV 바이러스는 주로 겨울철에 유행하며 감기와 유사한 증상을 나타냅니다.
특히 영유아와 면역력이 약한 노인에게 위험할 수 있어, 정확한 정보와 대처법을 아는 것이 중요합니다.
이번 글에서는 RSV의 특징, 예방 방법, 그리고 치료법까지 알아보겠습니다.
1. RSV 바이러스란 무엇인가요?

RSV는 "호흡기세포융합바이러스"의 약자로, 호흡기 질환을 유발하는 주요 바이러스 중 하나입니다.
감기처럼 시작되지만, 특히 영유아에게는 세기관지염, 폐렴 등으로 진행될 수 있습니다.

전파 경로
RSV는 감염자의 기침, 재채기, 또는 바이러스에 오염된 물체를 만졌을 때 전파됩니다.
아이들의 장난감, 물병 등은 주요 감염원이 될 수 있습니다.
주요 증상
초기: 콧물, 기침, 미열 심각 단계: 호흡곤란, 숨 가쁨, 청색증



2. RSV와 일반 감기의 차이점
RSV는 감기와 비슷한 증상을 보이지만, 두 질병에는 다음과 같은 차이점이 있습니다.
| 구분 | 일반 감기 | RSV |
|---|---|---|
| 주 대상군 | 전 연령대 | 영유아, 노인 |
| 주요 증상 | 콧물, 기침, 열 | 숨소리 거침, 폐렴 가능성 |
| 합병증 발생 가능성 | 드뭄 | 높음 |
구분 일반 감기 RSV 주 대상 군 전 연령대 영유아, 노인 주요 증상 콧물, 기침, 열 숨소리 거침, 폐렴 가능성 합병증 발생 가능성 드묾 높음
3. RSV 예방 방법
RSV는 예방이 중요한 바이러스입니다. 다음의 습관이 큰 도움이 됩니다.
손 씻기
외출 후 손을 깨끗이 씻습니다.
마스크 착용
감염자와 접촉하지 않도록 주의합니다.
주변 환경 소독
장난감, 가구를 정기적으로 소독합니다. 백신 접종: 고위험군은 RSV 예방 백신 접종이 권장됩니다.
4. RSV 감염 시 치료법
현재 RSV를 치료하는 특별한 항바이러스제는 없습니다.
따라서 증상을 관리하는 방식으로 치료를 진행합니다.
가정 치료법
충분한 수분 섭취 실내 공기 촉촉하게 유지 열이 나는 경우 해열제 복용
의료 치료
산소 치료 중증일 경우 입원 치료
5. RSV 감염 예방 제품 추천
어린이 전용 손 소독제 유아용 가습기



RSV 바이러스는 감기와 유사하지만 더 심각한 합병증을 유발할 수 있습니다.
특히 영유아와 노인을 보호하기 위해서는 위생 관리와 예방 접종이 필수입니다.
오늘 소개한 내용을 참고하여 건강을 지키시길 바랍니다.
'생활 건강' 카테고리의 다른 글
| 프로폴리스 스프레이, 40대 여성의 겨울철 건강 필수템 (1) | 2024.11.29 |
|---|---|
| 겨울철 면역력 강화 식품, 추천 리스트 TOP 6 (5) | 2024.11.29 |
| 메디폼과 듀오덤 차이점, 무엇이 더 좋을까? (0) | 2024.11.28 |
| 슬리피솔 사용법과 효과 총정리 (0) | 2024.11.28 |
| 비오틴 효능부터 부작용 5가지 (0) | 2024.11.28 |